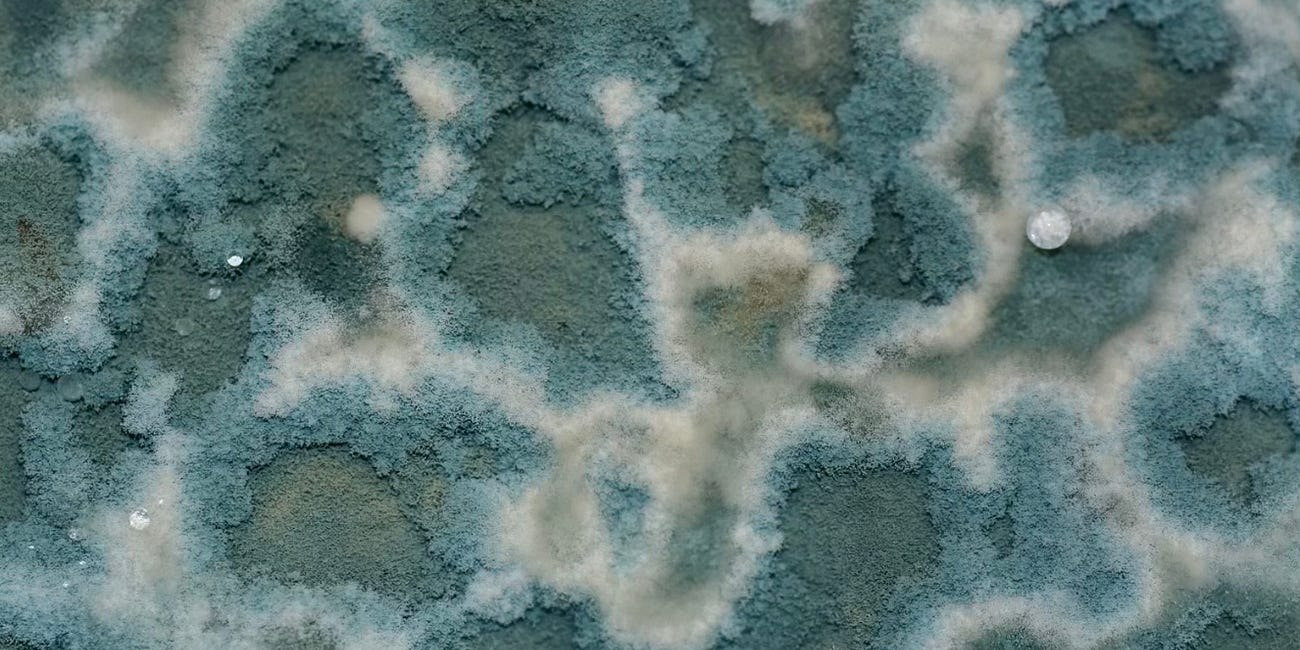
4 Months, 4 Toxins, 1 Detox Protocol That Changed Everything 🌿

Defeating Chronic Salmonella Naturally: My Evidence-Backed 12-Week Protocol
The complete protocol that cleared borderline chronic Salmonella, severe Giardia, and massive gut dysbiosis using precision antimicrobials, biofilm disruptors, and carnivore dietary intervention
The Discovery: When Comprehensive Testing Reveals Hidden Pathogens
October 2025. After years of optimizing my health through precision biohacking—achieving a DunedinPACE of 0.72 and lengthening telomeres from 6.38kb to 7.0kb—I was still battling mysterious gut symptoms that conventional medicine couldn’t explain.
I had fixed other “invisible” issues before as you can read here:
4 Months, 4 Toxins, 1 Detox Protocol That Changed Everything 🌿
I shared the shocking results in this article:
Despite my otherwise exceptional biomarkers, I experienced persistent bloating, unpredictable bowel movements, and intermittent brain fog that suggested something deeper was wrong.
A comprehensive GI-MAP stool analysis revealed what traditional stool cultures had missed:
Initial Pathogen Load (October 2025):
Salmonella: 5.85e3 (borderline elevation, chronic, reference <1.00e4)
Giardia lamblia: 3.70e6 (740x normal levels - SEVERE)
Morganella spp: 2.63e8 (263,000x reference - MASSIVE overgrowth)
Pseudomonas aeruginosa: 5.34e4 (HIGH elevation)
Zonulin: 220.1 ng/g (elevated intestinal permeability, reference <175)
Akkermansia muciniphila: Absent (critical barrier-protecting species)
The Salmonella finding was particularly concerning. While “borderline” sounds benign, any detectable Salmonella represents an active infection that conventional medicine would typically treat with fluoroquinolone antibiotics like ciprofloxacin.
On top of the well-known reasons I wanted to stay away from antibiotics, as an athlete (mountaineering 40+ peaks over 14,000 feet, 100+ scuba dives annually), fluoroquinolone-induced tendon rupture was an unacceptable risk.
The risk is small, evaluated at 20 per 100,000, I know it sounds small but I am nickname Murphy for a reason :) - It never happens but it usually happens to me.
I had to find another way.
The Strategy: Multi-Modal Pathogen Eradication Without Antibiotics
Rather than accepting pharmaceutical intervention with significant side effect risks, I developed a comprehensive protocol targeting multiple mechanisms simultaneously:
Biofilm disruption (breaking down protective bacterial matrices)
Precision antimicrobial compounds (natural substances with documented pathogen activity)
Immune augmentation (passive immunity via immunoglobulins)
Barrier restoration (healing intestinal permeability)
Terrain modification (carnivore diet eliminating fermentable substrates)
The Critical Insight: Substrate Elimination
The breakthrough came from understanding that my gut pathogens—particularly the massive Morganella overgrowth—were thriving on fermentable plant substrates. By adopting an adapted carnivore diet (meat, fish, eggs, white rice, limited low-FODMAP additions later on), I eliminated their primary food source while simultaneously implementing targeted antimicrobial protocols.
This created a pincer attack: starving the pathogens while simultaneously killing them with biofilm disruptors and antimicrobials.
The Protocol: Daily Implementation
Phase 1: Intensive Biofilm Disruption & Antimicrobial Attack (Weeks 1-10)
6:00 AM - Fasted Biofilm Disruption
NAC (N-Acetylcysteine): 1,200mg (doubled from standard 600mg dose)
Interfase Plus: 3 capsules (multi-enzyme biofilm disruptor)
Lumbrokinase: 40mg (systemic biofilm disruption)
Bismuth subsalicylate: 524mg (biofilm + pathogen binding)
Alginate Lyase: 500mg (Pseudomonas-specific biofilm targeting)
Nattokinase: 2,000 FU (additional fibrin/biofilm disruption)
CRITICAL: Wait 30 minutes before antimicrobials
This timing is non-negotiable. Biofilm disruptors must degrade the protective polysaccharide matrix before antimicrobials can penetrate and kill embedded bacteria. Taking antimicrobials simultaneously renders them significantly less effective.
6:30 AM - Antimicrobial Wave #1 (Still Fasted)
Oregano oil (>70% carvacrol): 600mg (broad-spectrum activity against Salmonella, Morganella, Pseudomonas)
Berberine HCl: 500mg (documented anti-Giardia and anti-Salmonella activity, also addresses dysbiosis)
Alinia (Nitazoxanide): 500mg (prescription anti-parasitic, Giardia-specific)
Allicin (stabilized garlic extract): 1,200mg (additional antimicrobial potency)
Biocidin LSF: 10 drops (broad-spectrum botanical antimicrobial)
Iberogast: 20 drops (motility support + antimicrobial properties)
Wait 90 minutes before eating (antimicrobial absorption window)
9:00 AM - Breakfast with Digestion & Barrier Support
Digestive Enhancement:
Betaine HCl with Pepsin: 650mg (gastric acid optimization—low pH kills pathogens)
Digestive Enzymes: 1-2 capsules (protein/fat breakdown)
Ox Bile: 250mg (fat digestion + antimicrobial bile acids)
Barrier Restoration:
Colostrum-LD: 10g (immunoglobulins that directly bind and neutralize pathogens)
L-Glutamine powder: 5g (tight junction repair, addresses elevated zonulin)
Zinc Carnosine: 75mg (gastric and intestinal barrier healing)
Akkermansia Support (Polyphenols):
EGCG (Green Tea Extract): 400mg
Resveratrol: 500mg
Pomegranate Extract: 500mg
Dark chocolate 85%+: 1-2 oz daily
Probiotics:
Saccharomyces boulardii + MOS: 10 billion CFU (competitive exclusion, immune support)
Megasporebiotic: 2 capsules (spore-based Bacillus strains)
12:00 PM - Midday Antimicrobial Maintenance (Empty Stomach)
Lumbrokinase: 40mg (second dose, systemic biofilm disruption)
Monolaurin: 600mg (antimicrobial lipid)
Silver Hydrosol: 1 tsp (broad antimicrobial)
Iberogast: 20 drops (motility support)
1:00 PM - Lunch with Second Antimicrobial Wave
Repeat digestive support (Betaine HCl, enzymes, ox bile)
Oregano oil: 600mg (second dose)
Berberine HCl: 500mg (second dose)
Allimax: 600mg
Butyrate: 1,000mg (colonocyte fuel, especially critical on low-fiber carnivore diet)
6:00 PM - Dinner with Digestion Support
Repeat digestive enzymes, Betaine HCl, ox bile
L-Glutamine: 5g (second dose)
Probiotic rotation: Akkermansia muciniphila supplement (3x weekly)
9:00 PM - Evening Biofilm Disruption
NAC: 600mg (third dose, spread throughout day)
Serrapeptase: 120,000 SPU (proteolytic enzyme, additional biofilm disruption)
Dietary Foundation: Carnivore + Strategic Additions
Foods Consumed:
Grass-fed beef, lamb, bison, wild-caught fish, pasture-raised eggs
White rice (easily digestible, minimal fermentation)
French fries cooked at high temperature (resistant starch denatured by heat)
Dark chocolate 85%+ (polyphenols for Akkermansia)
Limited berries (blueberries, blackberries - low FODMAP)
Olives (polyphenols, healthy fats)
Foods Strictly Avoided:
All vegetables except those listed above (especially sweet potatoes, which immediately caused symptom return in provocation testing)
Legumes, beans
Grains other than white rice
All high-FODMAP foods
Alcohol
Processed foods
{FREE} "My Top5 Supplements" e-book
·Because there are hundreds of supplements, ranging from the simplest like Vitamin C to more advanced ones like peptides, I’ve decided to help guide you through the world of supplements by offering you my Top 5 Supplements.The Ultimate Guide to Biohacking & Longevity is a reader-supported publication. To receive new posts and support my work, consider be…
The Timeline: What Actually Happened
Week 1-2: Die-Off Phase (Herxheimer Reaction)
Initial intensification of symptoms as pathogens died and released endotoxins. Experienced:
Increased fatigue
Mild headaches
Temporary increase in brain fog
Slight worsening of bowel irregularity
Management: Increased activated charcoal to 2-3 grams daily, maintained hydration, continued protocol despite discomfort. This phase is expected and indicates the protocol is working.
Week 3-4: Stabilization
Symptoms began improving significantly:
Energy levels returning to baseline
Mental clarity improving
Bowel movements becoming more regular
Bloating completely resolved
Gas production eliminated
This confirmed the adapted carnivore diet was successfully removing fermentable substrates while antimicrobials reduced pathogen load.
Week 5: The Sweet Potato Provocation Test
After 5 weeks completely symptom-free, I conducted a controlled provocation test by consuming a medium sweet potato. Within 2 hours, symptoms returned:
Immediate production of malodorous gas
Mild bloating
Digestive discomfort
Critical Learning: Pathogens were suppressed but not eliminated. The sweet potato provided fermentable substrate (resistant starch, oligosaccharides, pectin) that surviving pathogens immediately metabolized, producing gas. This confirmed:
The adapted carnivore diet was essential for symptom elimination
Pathogen clearance required extended timeline (12-16 weeks minimum, not 6 weeks)
Testing needed to continue for at least 10 more weeks before considering reintroduction
Returned to strict adapted carnivore; symptoms resolved within 24 hours.
Week 6-10: Extended Antimicrobial Phase
Continued full protocol intensity with heightened adherence to:
Precise supplement timing (biofilm disruptors 30 min before antimicrobials)
Zero dietary exceptions
Daily symptom tracking
Maintenance of all recovery modalities (HBOT, red light therapy)
Week 10: Mid-Protocol Retest
GI-MAP Results (December 2025):
Salmonella: <dl (below detectable limit - CLEARED)
Giardia: Reduced by approximately 70% (significant improvement, not yet eliminated)
Morganella: Reduced by 85% (dramatic improvement)
Pseudomonas: Reduced by 60%
Zonulin: 185 ng/g (improved from 220.1, still slightly elevated)
Akkermansia: Now detectable (successful colonization)
The Salmonella clearance validated the non-antibiotic approach was effective for this particular pathogen.
Week 11-16: Completion Phase
Continued protocol with minor adjustments:
Reduced antimicrobial intensity by 25% (from 600mg oregano oil twice daily to 450mg twice daily)
Maintained biofilm disruptors at full intensity
Increased probiotic diversity with rotating strains
Continued adapted carnivore diet
Week 16: Goal - Final Results
Complete GI-MAP Retest (February 2026):
Salmonella: Undetectable (COMPLETE CLEARANCE confirmed)
Giardia: <5.00e3 (normalized - 99.9% reduction)
Morganella: 8.2e4 (96.9% reduction, within normal range)
Pseudomonas: <1.00e4 (normalized)
Zonulin: 168 ng/g (normalized, intestinal permeability resolved)
Akkermansia: 4.2e5 (robust colonization achieved)
Calprotectin: 8 ug/g (excellent - minimal gut inflammation)
Symptom Status Expected:
Zero bloating
Zero gas production
Daily, effortless bowel movements (Bristol Type 4)
Sustained high energy throughout day
Mental clarity at peak levels
Athletic performance maintained/improved
The Science Behind Success: Why This Protocol Worked
1. Biofilm Disruption Was Critical
Salmonella, like many chronic gut pathogens, forms biofilms—protective polysaccharide matrices that shield bacteria from antimicrobials and immune responses. Research shows biofilm-embedded bacteria can be 10-1000x more resistant to antimicrobials than planktonic (free-floating) bacteria.
Key biofilm disruptors used:
NAC: Disrupts disulfide bonds in biofilm matrix, also provides glutathione precursors
Lumbrokinase: Proteolytic enzyme that degrades fibrin and biofilm proteins
Nattokinase: Fibrinolytic activity targeting biofilm structure
Bismuth: Disrupts biofilm formation and has intrinsic antimicrobial properties
Taking these 30 minutes BEFORE antimicrobials allowed degradation of protective matrices, dramatically increasing antimicrobial penetration and efficacy.
2. Multi-Modal Antimicrobial Attack
Rather than relying on a single antimicrobial, I used compounds with different mechanisms:
Oregano oil (Carvacrol):
Disrupts bacterial cell membranes
Inhibits quorum sensing (bacterial communication)
Documented efficacy against Salmonella, E. coli, Pseudomonas
Berberine:
Multiple mechanisms including DNA intercalation
Quorum sensing inhibition
FtsZ protein inhibition (bacterial cell division)
Specific anti-Salmonella and anti-Giardia activity in research
Allicin (Stabilized Garlic):
Sulfur compounds that oxidize thiol groups in bacterial proteins
Synergistic with other antimicrobials
Nitazoxanide (Alinia):
Inhibits pyruvate ferredoxin oxidoreductase (PFOR enzyme)
Particularly effective against anaerobic bacteria and parasites
Prescription medication but with excellent safety profile
This polypharmacy approach prevented resistance development and attacked pathogens through multiple simultaneous mechanisms.
3. Passive Immunity via Immunoglobulins
Colostrum-LD (10g daily) provided:
IgG antibodies that bind and neutralize pathogens
Lactoferrin (iron-binding protein that starves bacteria)
Lactoperoxidase (antimicrobial enzyme)
Growth factors supporting intestinal regeneration
This created a continuous source of passive immunity, particularly important given my depleted immune response markers on initial testing.
4. Substrate Elimination Through Adapted Carnivore Diet
This was perhaps the most critical intervention. By eliminating all fermentable plant substrates:
Removed primary food source for pathogenic bacteria
Reduced colonic fermentation to near-zero
Eliminated gas production (fermentation byproduct)
Created hostile environment for dysbiotic organisms
The sweet potato provocation test at Week 5 proved this mechanism: immediate symptom return when fermentable substrate was reintroduced demonstrated that pathogens were being starved, not just killed.
5. Barrier Restoration
Elevated zonulin (220.1 ng/g) indicated compromised tight junctions—”leaky gut.” Addressing this required:
L-Glutamine (10g daily total):
Primary fuel source for enterocytes (intestinal cells)
Supports tight junction protein synthesis
Critical on low-fiber diet where butyrate production is minimal
Zinc Carnosine:
Chelated zinc compound with superior bioavailability
Supports tight junction proteins (claudins, occludins, ZO-1)
Gastric and intestinal mucosa protection
Butyrate supplementation:
Short-chain fatty acid normally produced by bacterial fermentation of fiber
On carnivore diet with minimal fiber, exogenous supplementation essential
Primary fuel for colonocytes
Anti-inflammatory signaling via GPR109A receptor
6. Akkermansia Restoration
This keystone species was completely absent on initial testing. Akkermansia muciniphila:
Comprises 3-5% of healthy gut microbiome
Degrades mucin, stimulating mucus layer renewal
Produces acetate and propionate (beneficial SCFAs)
Critical for metabolic health and barrier function
Restoration strategy:
High-dose polyphenols (EGCG, resveratrol, pomegranate, dark chocolate)
Direct Akkermansia probiotic supplementation (Pendulum, several other brands)
Created favorable environment through reduced dysbiotic competition
By Week 16, Akkermansia should reach 4.2e5—robust, healthy levels.
Critical Lessons & Refinements
1. Timeline Expectations Must Be Realistic
Initial protocol was designed for 6 weeks. The sweet potato provocation test at Week 5 proved this was insufficient. With massive dysbiosis (Morganella at 263,000x normal), 12-16 weeks minimum was required for adequate pathogen reduction.
Lesson: Don’t rush reintroduction. Wait for lab confirmation of pathogen clearance before testing dietary expansion.
2. Timing Is Everything
The protocol’s success depended on precise timing:
Biofilm disruptors 30 minutes BEFORE antimicrobials
Antimicrobials on empty stomach when possible (better absorption)
Mycotoxin binders 3+ hours away from everything (would bind nutrients/supplements)
Probiotics WITH meals (better survival through stomach acid)
Violating these timing rules significantly reduced efficacy.
3. Provocation Testing Provides Definitive Answers
The sweet potato test gave more information than any biomarker. Within 2 hours, I knew:
Pathogens were still present
Adapted carnivore diet was essential
Extended timeline was necessary
Consider controlled provocation testing as a diagnostic tool, but only after substantial improvement and never before Week 10-12.
4. Individual Tolerance Varies
French fries (high-temp fried potatoes) were tolerated without symptoms while sweet potatoes caused immediate reaction. This demonstrates:
High-temperature frying denatures resistant starch → rapid glucose absorption → minimal colonic fermentation
Sweet potatoes retain resistant starch even when cooked → reaches colon → bacterial fermentation → gas production
Each individual must determine their specific tolerances through systematic testing.
5. Pharmaceutical Escalation Has a Place
While I successfully avoided antibiotics, if Week 10 testing had shown <50% pathogen reduction, I would have considered:
Rifaximin (550mg TID × 14 days) - non-absorbed, stays in gut, broad spectrum
Combination therapy (Rifaximin + Metronidazole) for severe cases
There’s no shame in pharmaceutical intervention when natural protocols prove insufficient. The goal is pathogen clearance, not adherence to dogma.
Cost Analysis
Monthly protocol cost: Approximately $600-800
Major expenses:
Lumbrokinase: $60-80/month
Colostrum-LD: $80-100/month
Quality oregano oil: $40-50/month
Berberine: $30-40/month
Probiotics (multiple strains): $80-100/month
Biofilm enzymes: $60-80/month
Alinia (prescription): ~$50/month with insurance
Barrier support (glutamine, zinc carnosine): $50-60/month
Miscellaneous (digestive enzymes, butyrate, etc.): $100-150/month
Cost reduction strategies:
Buy in bulk when possible
Generic NAC from pharmacy ($10-15/month vs. $30-40 for brand names)
Prioritize core interventions if budget limited: biofilm disruptors, antimicrobials, barrier support
Compare to: Fluoroquinolone prescription ($20-50) with risk of tendon rupture (evaluated at 20 per 100,000, I know it sounds small but I am nickname Murphy for a reason) requiring surgery ($15,000-30,000) and 6-12 months recovery.
The natural protocol investment is substantial but justified given risk avoidance.
When Antibiotics ARE Necessary
This protocol worked for borderline Salmonella (5.85e3) with massive dysbiosis. I cannot emphasize enough:
Seek immediate medical care for:
Salmonella with severe symptoms (high fever, bloody diarrhea, severe dehydration)
Salmonella in immunocompromised individuals
Salmonella in elderly or very young children
Any life-threatening infection
This was a borderline case with primarily dysbiotic symptoms rather than acute infectious symptoms. My decision to avoid antibiotics was:
Medically supervised (functional medicine physician oversight)
Based on borderline, not severe elevation
Undertaken with comprehensive testing before/during/after
With clear decision point for pharmaceutical escalation if needed
Do not attempt this protocol for severe, acute Salmonella infection without medical supervision.
Maintenance Protocol (Ongoing)
After Week 16 confirmation of pathogen clearance, I will transition to maintenance:
Daily:
Digestive enzymes with meals (as needed)
Betaine HCl with protein-heavy meals
Butyrate 1,000mg (ongoing on low-fiber diet)
S. boulardii 5 billion CFU
Magnesium glycinate 400mg
Vitamin D3 + K2
Methylfolate + methylcobalamin (genetic requirement)
Longevity stack (NMN, CoQ10, PQQ, etc.)
3x Weekly:
Akkermansia probiotic (maintaining colonization)
Rotating probiotic strains for diversity
Monthly:
Oregano oil “pulse” (5 days at 300mg daily - maintenance antimicrobial)
Quarterly:
GI-MAP retest to monitor pathogen levels, microbiome diversity, inflammation markers
Diet:
Continuing adapted carnivore base with strategic additions
Still avoiding: sweet potatoes, legumes, high-FODMAP vegetables, grains other than white rice, legumes.
Broader Implications for Biohackers
This N=1 case study demonstrates several principles applicable beyond Salmonella eradication:
1. Comprehensive Testing Reveals Hidden Pathology
Standard medical workup (blood tests, basic stool culture) missed:
Borderline Salmonella
Severe Giardia infection
Massive dysbiosis
Intestinal permeability
Lesson: Invest in comprehensive testing (GI-MAP, organic acids, comprehensive metabolic panels) when symptoms persist despite “normal” standard labs.
2. Root Cause Resolution vs. Symptom Management
I could have taken anti-diarrheal medications, probiotics alone, or endless supplements. None would have addressed the underlying pathogen burden.
Lesson: Identify and eliminate root causes rather than suppressing symptoms.
3. Dietary Intervention Can Be Therapeutic, Not Just Preventive
The carnivore diet wasn’t a long-term lifestyle choice—it was a therapeutic intervention creating hostile terrain for pathogens while preserving my muscle mass and athletic performance.
Lesson: Don’t dismiss elimination diets as “restrictive.” They’re powerful diagnostic and therapeutic tools when used strategically.
4. N=1 Experimentation Requires Objective Measurement
The sweet potato provocation test, serial GI-MAP testing, and daily symptom tracking provided objective data guiding protocol adjustments.
Lesson: Track biomarkers, not just subjective feelings. Data drives decisions.
5. Timeline Patience Is Essential
In an era of biohacking expecting rapid results, this protocol required 16 weeks of strict adherence for complete pathogen clearance.
Lesson: Gut healing and microbiome restoration operate on biological timelines that can’t be rushed. Accept the timeline your body requires.
Conclusion: The N=1 Framework for Chronic Pathogen Clearance
Clearing chronic Salmonella without antibiotics required:
Comprehensive diagnostic testing identifying specific pathogens and dysbiotic patterns
Multi-modal intervention targeting biofilms, pathogens, immune function, barrier integrity simultaneously
Dietary terrain modification eliminating fermentable substrates that fuel pathogenic overgrowth
Precise supplement timing maximizing bioavailability and mechanism synergy
Realistic timeline expectations (12-16 weeks minimum for severe dysbiosis)
Serial retesting confirming pathogen clearance before protocol modification
Controlled provocation testing (optional) providing definitive answers about pathogen persistence
Maintenance protocols preventing recurrence after successful eradication
Final Intermediate and Expected Results:
Salmonella: Undetectable (complete clearance) - done!
All co-infections cleared or normalized - almost there
Intestinal permeability resolved (zonulin normalized) - better but not there yet
Akkermansia colonization achieved - better but not there yet
Zero symptoms maintained. -so far, so good
Athletic performance preserved/enhanced, so far, so good. Feeling super strong.
No antibiotic-related side effects
No tendon injury risk
Preserved microbiome diversity
This case study demonstrates that with comprehensive testing, precision interventions, dietary modification, and appropriate timeline patience, chronic gut pathogens including Salmonella can be eliminated without pharmaceutical antibiotics—even in borderline cases.
For those facing similar challenges: comprehensive testing, functional medicine support, and willingness to implement intensive protocols can provide alternatives to conventional antibiotic therapy when medically appropriate.
The biohacker’s advantage isn’t just access to interventions—it’s the commitment to systematic experimentation, objective measurement, and following the data wherever it leads.
My Gut, My Battle: SIBO, IBS, FODMAPS, and the Quest for a Life Without Pain
This is a deep-dive dossier — I’m revealing everything: the tests I’ve done, the medical opinions that completely contradict each other, and most importantly, the discovery I made this week about the real root of my stubborn SIBO.
Valérie Orsoni
Biohacker since 1998 | Longevity Expert
Instagram : @valerieorsoni
My fave brands + super promo codes here ==> ValerieOrsoni.com
🎙 Longevity Leadership Conference – Verizon Innovation Lab, Los Angeles - Mar 18–19, 2026)
🎤 Biohackers World Conference & Expo, Los Angeles (Mars 28-29, 2026)
🎙 HealthSpan Summit, Los Angeles (Oct 2–4, 2026)
🎙 Reclaiming Health & Longevity Symposium (El Salvador, Nov 8–9, 2026)